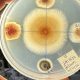
Universidad chilena busca controlar el revirado del pino con hongos endófitos

La infección genera tumores y malformaciones fustales
Universidad chilena busca controlar el revirado del pino con hongos endófitos
La Universidad Austral de Chile (UACh) busca controlar el hongo Corincectria constricta con un biofungicida de cepas de hongos endófitos para proteger las heridas resultantes de la poda de los pinos radiata.
25 de Junio 2024
Equipo Redagrícola
La Facultad de Ciencias Forestales y Recursos Naturales de la Universidad Austral de Chile (UACh) desarrolla un proyecto de investigación para el control sustentable con hongos endófitos del patógeno Conrinectria constricta o Neonectria fuckeliana en plantaciones de







